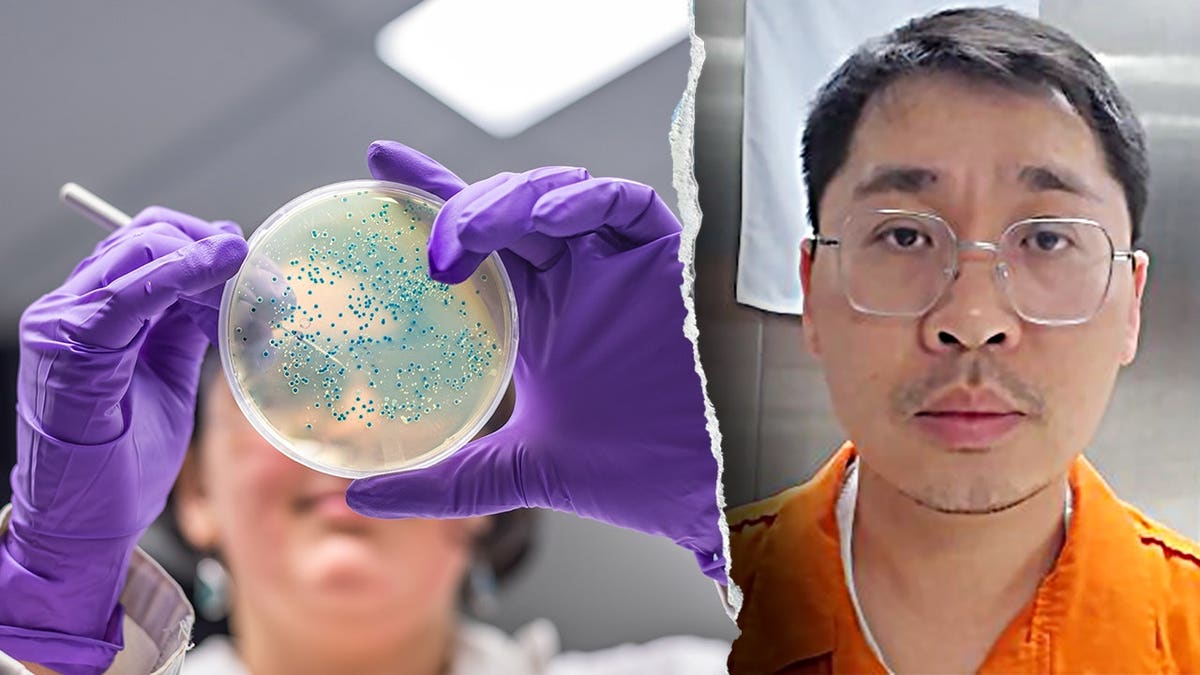
Split image of E. coli bacteria sample in a lab and Chinese researcher Youhuang Xiang

NEWYou can now listen to Fox News articles!
A Chinese researcher was sentenced to more than four months in prison after pleading guilty to smuggling Escherichia coli (E. coli) into the United States, federal prosecutors announced Tuesday.
Youhuang Xiang, 32, a former Indiana University postdoctoral researcher and Chinese national, admitted to concealing E. coli DNA in a shipment from China that was falsely labeled as women’s underwear, according to the U.S. Attorney’s Office for the Southern District of Indiana.
Prosecutors said the FBI also uncovered evidence that Xiang was a member of the Chinese Communist Party and had lied about that affiliation to immigration authorities. Authorities said the case raises concerns about public safety and the integrity of federally funded research.
“Such conduct poses a very serious threat to public safety and to the health of our agricultural economy,” U.S. Attorney Tom Wheeler said.
ELITE US COLLEGES LINKED TO CHINESE SURVEILLANCE LABS DRIVING UYGHUR ‘GENOCIDE,’ STUDY WARNS
Split image of E. coli bacteria sample in a lab and Chinese researcher Youhuang Xiang (iStock; FBI Indianapolis)
Authorities said Xiang received the package at his Bloomington, Indiana, residence in March 2024 after it was shipped from a China-based company and mislabeled on the manifest to avoid detection.
According to court documents, the FBI’s Indianapolis Division began investigating suspicious shipments from China to individuals affiliated with Indiana University in November 2025. Agents determined that Xiang had received a shipment from Guangzhou Sci-Tech Innovation Trading that was declared as “Underwear of Man-Made Fibers, Other Womens.” Investigators found the shipment unusual, given the company’s focus on science and technology products.
He was later stopped by U.S. Customs and Border Protection officers at Chicago O’Hare International Airport in November 2025 upon his return from a research trip to the United Kingdom. Authorities said he initially denied knowledge of the shipment before admitting the contents had intentionally concealed samples of DNA of E. coli bacteria, according to court documents.
E. coli is a bacteria that lives in the gut but can cause serious illness if harmful strains spread.
LAWMAKERS DEMAND ANSWERS AFTER SUSPECTED BIOLAB DISCOVERED IN CHINESE NATIONAL’S LAS VEGAS HOME

Chinese President Xi Jinping waves during a meeting with Vietnam’s communist party general secretary To Lam at the Office of the Party Central Committee in Hanoi on April 14, 2025. (Nhac Nguyen/AFP)
“Those who attempt to secretly bring biological materials into the United States are taking a serious risk with public safety,” FBI Indianapolis Special Agent in Charge Timothy J. O’Malley said.
A federal judge sentenced Xiang to more than four months in prison, along with a fine and supervised release, and ordered his removal from the United States following his sentence.
“This Chinese Communist Party member exploited a federally funded research grant… to smuggle dangerous biological material into the United States,” USDA Inspector General John Walk said.
The case is part of a broader pattern of recent prosecutions involving foreign researchers accused of smuggling biological materials into the U.S.
In November, federal prosecutors charged three Chinese nationals with conspiring to smuggle biological materials into the U.S. while working at the University of Michigan’s Shawn Xu Laboratory, alleging they made false statements to customs officials to bring in roundworm-related materials from China.
CLICK HERE TO DOWNLOAD THE FOX NEWS APP

Visa applicants line up at the U.S. embassy in China. (Mark Ralston/AFP/Getty Images)
Authorities said the suspects were participating in J-1 visa programs and allegedly received concealed shipments from a China-based researcher who had previously been convicted of similar offenses and removed from the U.S.
In a separate case in February 2025, a Russian-born Harvard researcher was detained at Boston Logan International Airport for allegedly smuggling frog embryos into the country without proper permits. Authorities said the materials were discovered after the scientist initially denied carrying biological substances. She was later released from federal custody while the case proceeds.

